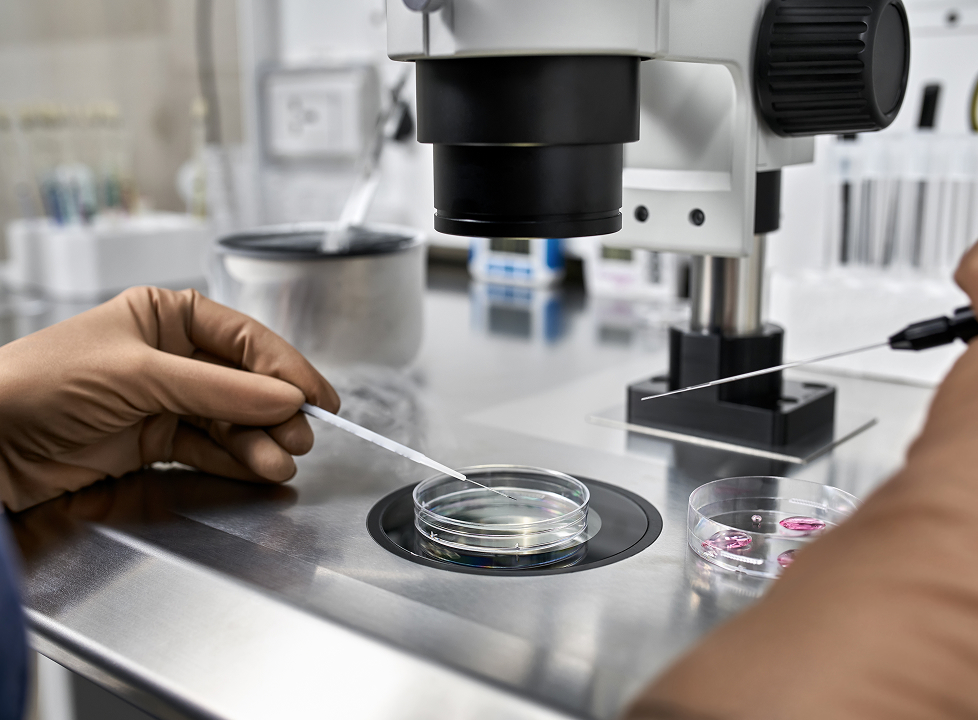
support-plan-1

サポートプラン
Support Plans
ひとりで悩まず、専門家と一緒に
妊活・妊娠・卵子凍結について考えるとき、いろいろな不安が頭をよぎります。
「医療のことはよくわからない」
「お金はどのくらいかかるの?」
「仕事と両立できるかな?」
「本当にこの選択でいいのかな...」
全部まとめて考えると、どこから手をつければいいかわからず迷ってしまうもの。Cuepodは、医療・お金・生活・心の専門家チームが一丸となり、あなたのペースに合わせて近い将来の整理をお手伝いします。
少しでも不安を減らし、これからの選択を前向きなものにしませんか?
トータルサポートプラン
ケアコーディネーターがあなたの目的に応じて、複数のテーマを組み合わせたトータルサポートプランをご提案します。
卵子凍結トータルサポートの例
マタニティトータルサポートの例
プレ妊活トータルサポートの例
- メンタルサポートセッション(臨床心理士・カウンセラー)
- メディカルカウンセリング(医師・希望者のみ)
- マネー・プランニング(ファイナンシャルプランナー)
- ウェルネスサポートセッション(栄養士)